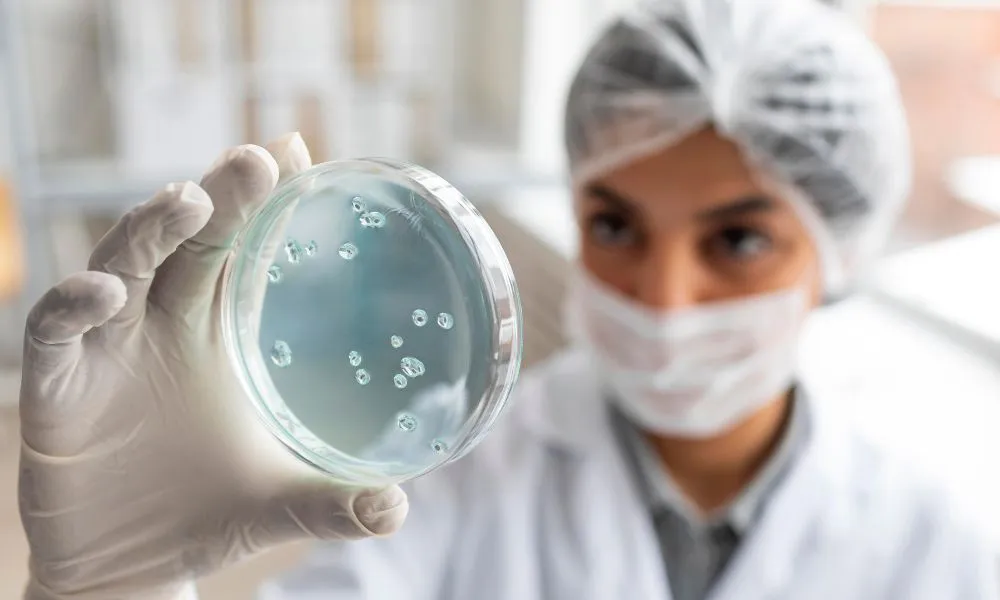
Descubrimientos que podrían transformar la inmunoterapia

Destacan avances en terapias inmunológicas para psoriasis, artritis y enfermedad intestinal
Actualidad10/09/2025
REDACCIÓN
Cuando se habla de psoriasis, artritis psoriásica y enfermedad inflamatoria intestinal, se piensa en condiciones distintas con síntomas y abordajes específicos de dermatología, reumatología y gastroenterología. Sin embargo, comparten mecanismos inmunológicos que generan procesos inflamatorios a partir de proteínas llamadas interleuquinas. Esa base común abre la puerta a terapias capaces de bloquear los factores que impulsan la enfermedad.
El tema fue eje del Inmuno Summit 2025 “Hacia una atención integral del paciente”, que reunió a más de 400 especialistas de Argentina y Chile en el Centro de Convenciones de Buenos Aires. Allí se compartieron avances en investigación y estrategias interdisciplinarias para mejorar la calidad de vida. El encuentro contó con referentes de gran trayectoria internacional.
“Es importante destacar los esfuerzos continuos en la investigación de enfermedades inmunológicas que traducen los principales avances científicos en tratamientos reales”, señaló el Dr. Steven Fakharzadeh, de Johnson & Johnson. Remarcó que el objetivo no es solo aliviar síntomas, sino restaurar la salud y lograr respuestas concretas y duraderas a lo largo del tiempo mediante nuevas terapias innovadoras.


OTRAS NOTICIAS:
El especialista costarricense Dr. Kenneth Ernest-Suárez destacó que la llegada de nuevas moléculas cambió el techo terapéutico en enfermedad inflamatoria intestinal. Hace una década el objetivo era que el paciente no tuviera síntomas, luego que las endoscopías mostraran mejoría, pero hoy se alcanzan tasas de remisión endoscópica mucho más altas. Incluso, se trabaja para lograr la remisión histológica.
“La experiencia en el tratamiento de Crohn nos muestra que uno de cada tres pacientes logró remisión profunda, lo que antes era impensado”, indicó Ernest-Suárez. Estos avances están cambiando la forma de entender la evolución de la enfermedad y amplían los horizontes de la práctica médica. La expectativa ahora se centra en superar resultados que hace unos años eran inimaginables.
En el panel local participaron especialistas como Gabriel Magariños, Enrique Soriano y Maricel Bellicoso, junto a expertos internacionales como Pedro Herranz y José Uriel Scher. El intercambio interdisciplinario permitió analizar cómo cada área aporta herramientas complementarias. El consenso fue que la atención integral mejora la respuesta terapéutica.
OTRAS NOTICIAS:
La psoriasis afecta a entre el 2 y el 3% de los argentinos y se manifiesta con lesiones rojas y escamosas en distintas partes del cuerpo. La artritis psoriásica compromete las articulaciones, genera dolor e hinchazón y en muchos casos aparece junto a la psoriasis. La enfermedad inflamatoria intestinal, en tanto, incluye Crohn y colitis ulcerosa, con síntomas como diarrea, dolor abdominal, pérdida de peso y complicaciones extraintestinales.
Los especialistas coincidieron en que factores como infecciones, consumo de alcohol o tabaco, estrés o cambios hormonales pueden actuar como disparadores. Estas condiciones no son contagiosas, pero requieren diagnósticos tempranos y tratamientos adecuados para evitar complicaciones graves. El objetivo es reducir daños progresivos y prevenir la discapacidad.
El cierre del encuentro estuvo a cargo de Ariel Perelsztein, de J&J Innovative Medicine, quien destacó que la compañía tiene “amplia experiencia en inmunología y cientos de miles de pacientes tratados en el mundo”. Subrayó que este tipo de espacios son esenciales para intercambiar experiencias y consolidar nuevos abordajes. El mensaje final apuntó a reforzar la cooperación internacional en beneficio de los pacientes.
Fuente: NA.














